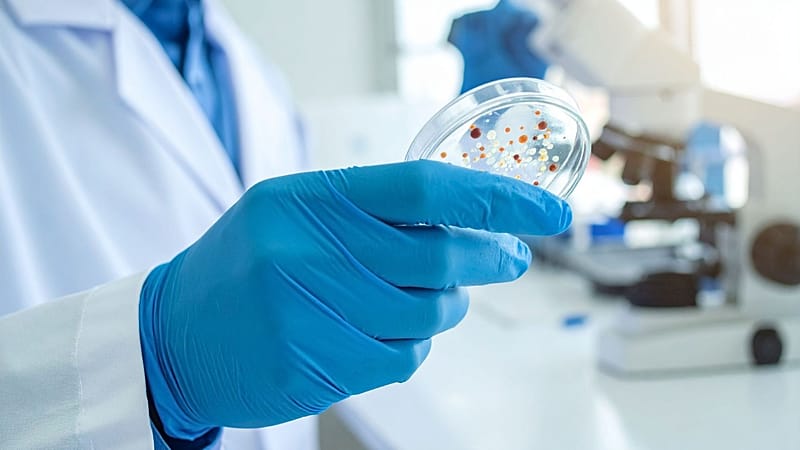
1

Could AI help defeat antibiotic-resistant superbugs? UK scientists are trying to find out
Scientists in the United Kingdom will soon use artificial intelligence (AI) to combat the rising threat of infections that are resistant to treatment.
Antimicrobial resistance (AMR) occurs when pathogens such as bacteria or viruses evolve to the point where they can evade existing drugs, making infections harder to treat. People speed up this process by overusing antibiotics in health care and farming.
An estimated one in six lab-confirmed bacterial infections are now resistant to antibiotics, global data shows, and AMR is expected to directly kill 39 million people through 2050.
The risks have sent scientists scrambling to develop new medicines – and now, they’re betting on AI to aid their search.
About 50 researchers will work on the three-year initiative, which launches early next year with £45 million (€51 million) from pharmaceutical giant GSK. The drugmaker partnered with the Fleming Initiative, a UK group that convenes scientists, policymakers, and health care industry players, for the programme.
“Antimicrobial resistance is one of the biggest challenges we face in the [National Health Service] and across the world,” said Tim Orchard, chief executive of Imperial College Healthcare NHS Trust, which helps run the Fleming Initiative.
“Drug-resistant infections are increasingly difficult to treat and pose a growing risk to patients,” Orchard added in a statement.
The researchers will focus on a handful of drug-resistant bugs that the World Health Organization (WHO) has identified as priority pathogens: Aspergillus, Gram-negative bacteria such as Escherichia coli (E. coli) and Klebsiella pneumoniae, and Staphylococcus aureus, including Methicillin-resistant Staphylococcus aureus (MRSA).
In one project, they will create an AI model to design and test new antibiotics against multi-drug-resistant Gram-negative infections. GSK said the data and AI models will be made available to scientists elsewhere in the world to speed up the development of next-generation treatments.
Another group will use AI to better understand how the immune system responds to S. aureus, so that scientists can create an effective vaccine against infections.
“We urgently need new solutions and interventions for tackling drug-resistant infections, which will only be achieved if we pool our expertise,” Orchard said.
Yesterday

